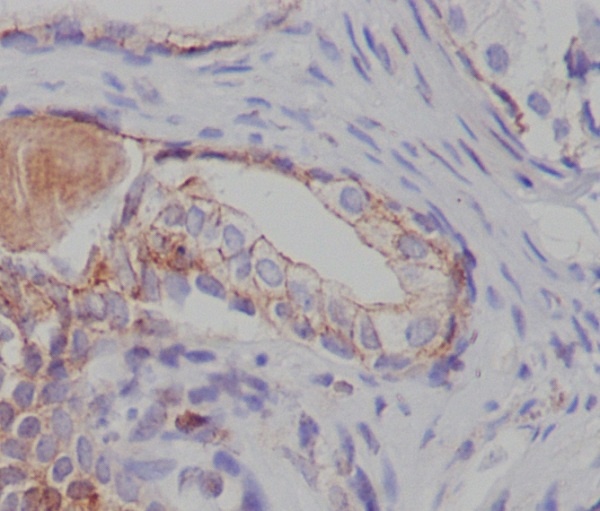

-
分类: 科研抗体货号: P17273别名: ACACA kinase; Acetyl-CoA carboxylase kinase; AMPK alpha 2 chain; AMPK subunit alpha-2; AMPK2; AMPKalpha2; HMGCR kinase; PRKAA; PRKAA2;;p-AMPK alpha 1/2 (T183/T172)应用: WB反应种属: Human,Mouse,Rat
-
分类: 科研抗体货号: P17254别名: Early endosome antigen 1; EEA1; MST105; ZFYVE2;;Early endosome antigen 1应用: WB,IF反应种属: Human,Mouse,Rat
-
分类: 科研抗体货号: P17266别名: HNC; CLG1; MMP-8; PMNL-CL; COLLAGENASE I; NEUTROPHIL; matrix metalloproteinase 8;;MMP8应用: WB,IHC/IHF,IF,IP,FCM反应种属: Human,Mouse,Rat
-
分类: 科研抗体货号: P17253别名: AF6q21 protein; FKHR2; FKHRL1; Forkhead box O3; forkhead box O3A; Forkhead box protein O3A; Forkhead in rhabdomyosarcoma-like 1; FOXO3A;;p-FOXO3A (S253)应用: WB;IHC反应种属: Human,Mouse,Rat
-
分类: 科研抗体货号: P17272别名: HBA2; Alpha globin; Alpha-2 globin; HBH; Hemoglobin alpha chain; Hemoglobin A1c; Hemoglobin subunit alpha; Hemoglobin alpha 2; Alpha-globin;;Hemoglobin alpha应用: WB;IHC;IP;FCM反应种属: Human,Mouse,Rat
-
分类: 科研抗体货号: P17265别名: BCL2A1; ACC-1; ACC-2; Bcl-2-like protein 5; Bcl-2-related protein A1; BCL2-related protein A1; BFL1; Bcl2-L-5; BCL2L5; GRS; HBPA1; Protein BFL-1; Protein GRS;;Bcl 2 A1应用: WB,IHC/IHF,IF,FCM反应种属: Human,Mouse,Rat
-
分类: 科研抗体货号: P17251别名: Oncogene PIM1; PIM; pim-1 kinase 44 kDa isoform; pim-1 oncogene; pim-1 oncogene (proviral integration site 1); PIM1;;PIM1应用: WB,IHC/IHF,IF,反应种属: Human,Mouse
-
分类: 科研抗体货号: P17271别名: TSC2; Tuberous sclerosis 2 homolog protein; Tuberous sclerosis 2 protein; Tuberin;;Tuberin应用: WB;IHC;FCM反应种属: Human,Mouse,Rat
-
分类: 科研抗体货号: P17264别名: CMH-1; ICE-LAP3; MCH3; CASP7; Caspase-7; Caspase7;;Caspase 7应用: WB;IHC;IP反应种属: Mouse,Rat
-
分类: 科研抗体货号: P17279别名: STK3; Mess1; MST-2; MST2; Serine/threonine kinase 3; KRS1; STE20-like kinase MST2;;STK3应用: WB,IHC/IHF,IF,IP,FCM反应种属: Human,Mouse,Rat

鄂公网安备42018502007531号
鄂公网安备42018502007531号

